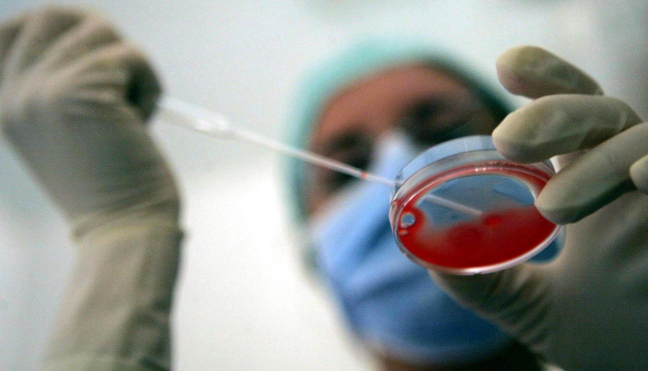

Il ministro Balduzzi, per realizzare in tempi brevi, come voluto dalla Roccella, la modifica di competenze esclusive su gameti e embrioni attribuendo competenze esclusive del Registro Nazionale PMA (ISS) al Centro Nazionale Trapianti, invia alla conferenza stato regioni un documento che ha le stesse finalità dell’atto di Governo 444, atto di forzatura normativa, che prevede che i dati sulla tracciabilità di gameti e embrioni non vengano più inviati al Registro Nazionale PMA presso l’ISS ma al Centro nazionale Trapianti che poi in subordine li trasmetterà all’ISS. Si distrugge così il lavoro che da anni il Registro PMA già effettua nel rispetto delle norme sulla privacy dei pazienti, come previsto dal Garante della Privacy.
Ma il ministro omette di allegare sia i pareri sia dell’ ISS, espressi in data 16 gennaio 2012, che quelli del CSS del 21 febbraio 2012, che indicavano entrambi come fosse essenziale l’ invio dei dati contestualmente al Registro PMA presso l’ISS e al CNT.
Se il Ministro omette è bene chiarire che non vi è competenza del Centro Nazionale Trapianti rispetto alle cellule riproduttive che non sono certo da considerarsi alla stregua di altre cellule o di organi per un trapianto, circostanza confermata inoltre nel DLGS 191/07 e 16/10 oltre che sancita dalla Legge sulla procreazione assistita.
Perché, ‘tecnicamente’, si vuole cambiare un sistema già in atto e funzionante che vede un sodalizio di collaborazione perfettamente funzionante fra ISS, Registro PMA e Regioni?
All’ISS competono, secondo la legge 40/2004 e per D.M. 7 ottobre 2005, oltre alla raccolta dati, altre varie funzioni, esercitate in stretta collaborazione con le Regioni: autorizzazioni, revoche, ispezioni, controlli
Chiedo al ministro Balduzzi, perché viene richiesto tale passaggio di dati dal CNT? Perché il ministro Balduzzi non agisce da tecnico su questo tema? Le coppie infertili e i loro bambini per quanto tempo dovranno essere trattati da cittadini senza diritti e subire ancora norme lesive dei loro diritti? Dovranno essere scoraggiati nel percorso genitoriale?
Le norme sulla sicurezza in materia di fecondazione assistita sono in linea con quanto ci chiede l’Europa. Perché il ministro Balduzzi lo ignora? Perché per conoscere lo stato di salute dell’embrione le coppie non possono usufruire della sanità pubblica?
Insomma se il Ministro vuole cambiare qualcosa è bene prima che capisca quali sono i reali problemi che concernono la fecondazione e non impieghi il suo tempo tecnico per fare politica astratta e lontana dai cittadini.